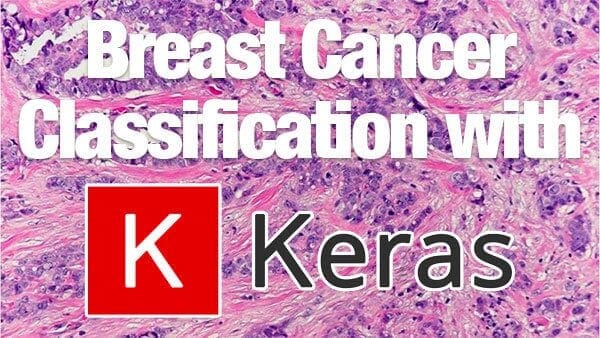

In this tutorial, you will learn how to use Keras for feature extraction on image datasets too big to fit into memory. You’ll utilize ResNet-50 (pre-trained on ImageNet) to extract features from a large image dataset, and then use incremental…

Keras: Feature extraction on large datasets with Deep Learning
Read More of Keras: Feature extraction on large datasets with Deep Learning